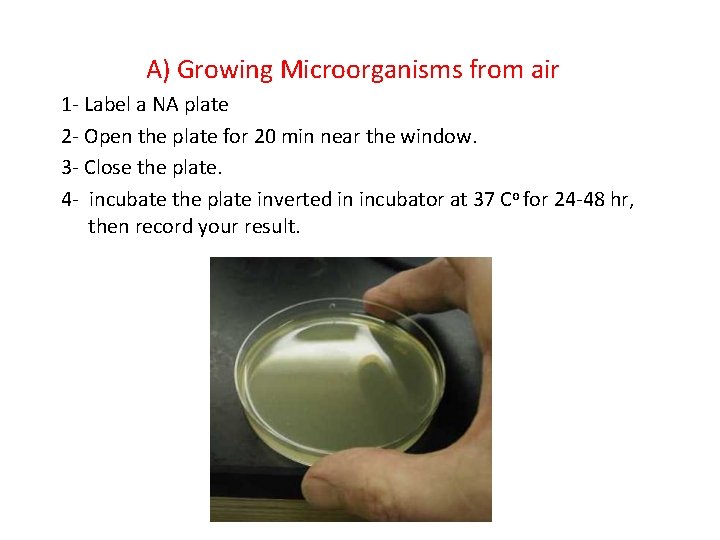
A) Growing Microorganisms from air 1 - Label a NA plate 2 - Open
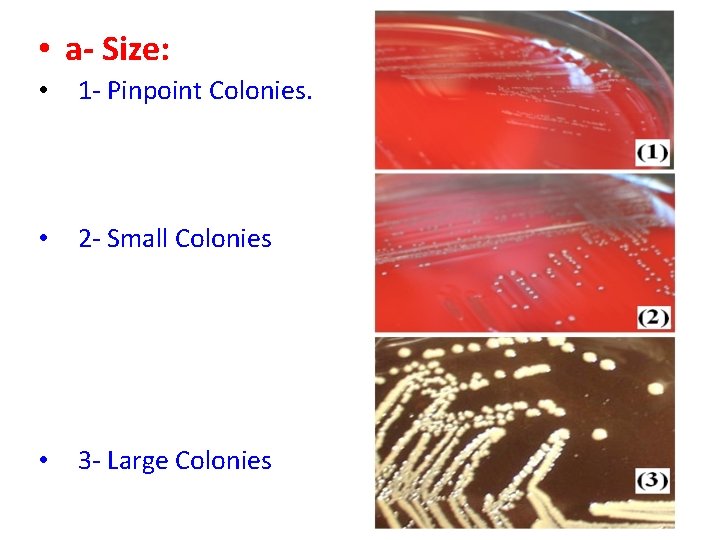
• a- Size: • 1 - Pinpoint Colonies. • 2 - Small Colonies
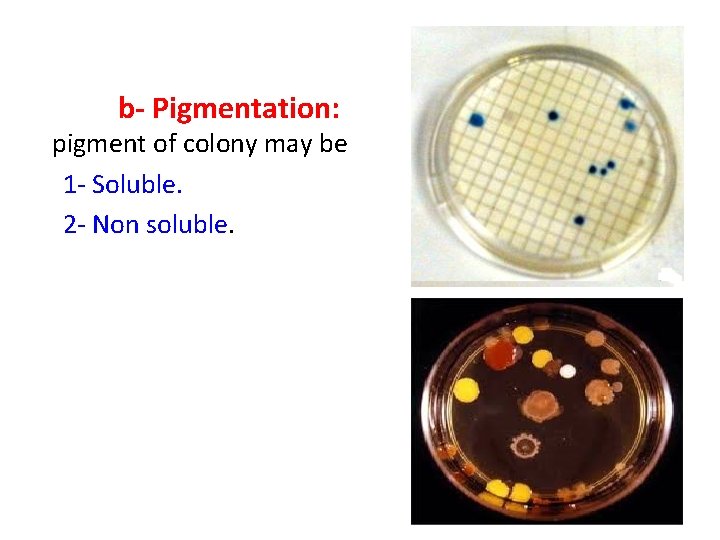
b- Pigmentation: pigment of colony may be 1 - Soluble. 2 - Non

Isolation of Bacteria by Dilution Technique Lab 2

Isolation of Bacteria by Dilution Technique Lab ( 2 )

Pure Culture: Contain a single kind of microorganism. It is important for the following concepts: 1 - Growth characteristics. 2 - Pathogenicity. 3 - Antibiotic susceptibility.

Dilution Methods: There are three dilution methods: 1 - Streaking plates. a) Quadrant Streaking Method. b) Radiant Streaking Method. 2 - Spreading plates. 3 - Pouring plates.

1 -Streaking method • Quadrant Streaking Method. 1. 2. 3. 4. 5. 6. 7. 8. Flame the loop and wire and streak a loopful of mixed broth culture as at A in the diagram. Reflame the loop and cool it. Streak as at B to spread the original inoculum over more of the agar. Reflame the loop and cool it. Streak as at C. Reflame the loop and cool it. Streak as at D. Label the plate and incubate it inverted in incubator at 37 Co for 24 hr, then record your result.

b) Radiant Streaking Method. 1. Flame the loop and wire and streak a loopful of mixed broth culture as at 1 in the diagram. 2. 4. Reflame the loop and cool it. Streak as at 2 to spread the original inoculum over more of the agar. Reflame the loop and cool it. 5. Streak as at 3. 6. Label the plate and incubate it inverted in incubator at 37 Co for 24 hr, then record your result. 3.

Microbes in the Environment source of contamination Lab ( 3 )

* Microbes are found every where; soil, water, air, and our bodies. * Microorganisms that found in a given situation like; intestine, soil, ……. etc are called (Flora). * Flora are found in specific area of body depending on some environmental factors such as: p. H, Oxygen concentration, moisture and type of secretion associated with that side.

• Normal Flora as located as follow: 1 - Skin: Staph. epidermidis, Yeasts, Fungi. 2 - Eye conjunctiva: Staphylococcus, Streptococci and Deptheroids. 3 - Upper respiratory tract: Staphylococcus, Streptococci (α hemolytic and non hemolytic) and Deptheroids. 4 - Mouth and Teeth: anaerobic dextran producing like Streptococci; Sterp. mutans.
A) Growing Microorganisms from air 1 - Label a NA plate 2 - Open the plate for 20 min near the window. 3 - Close the plate. 4 - incubate the plate inverted in incubator at 37 Co for 24 -48 hr, then record your result.

B) Growing bacteria from your finger. 1 - Using marker divide NA plate into two parts. 2 - Label it as in figure, before and after. 3 - Place your finger gently on the surface of agar, at the part labelled by before. 4 - Wash your hands with ethanol and repeat the step 3, but at part labelled by after. 4 - incubate the plate inverted in incubator at 37 Co for 24 -48 hr, then record your result.

Cultural characteristics of Microorganisms

- Microorganisms show differences in the microscopic appearance of their growth, these differences are called Cultural characteristics.

- Cultural characteristics: are used as a basic role in separating and isolating microorganisms from all types of media as: Nutrient slant agar. Nutrient plates agar. Nutrient Deep agar. Nutrient broth

• 1 - NA plates: • • a- Size: b- Pigmentation: pigment of colony may be soluble or non soluble. c- Form: The shape of colony d- margin: The outer edge of the colony e- Elevation: The degree of colony growth elevation on the agar surface. f- Surface and Consistency:
• a- Size: • 1 - Pinpoint Colonies. • 2 - Small Colonies • 3 - Large Colonies
b- Pigmentation: pigment of colony may be 1 - Soluble. 2 - Non soluble.

c- Form: The shape of colony • 1 - Circular • 2 - Irregular • 3 - Rhizoid: Root like

d- Margin: The outer edge of the • • colony 1 - Entire 2 - Lobate: marked indentation 3 - Undulate: Wavy indentation. 4 - Serrate: Tooth like appearance. 5 - Filamentous: Thread like appearance.

e- Elevation: The degree of colony growth elevation on the agar surface. • 1 - Flat. • 2 - Raised: Slightly elevated. • 3 - Convex: Dome shape • elevated. • 4 - Umbonate: Raise with • elevated convex central • region.

f- Surface and Consistency: • 1 - Powdery. • 2 - Wrinkled. • 3 - Smooth. • 4 - Glistening.
- Slides: 20